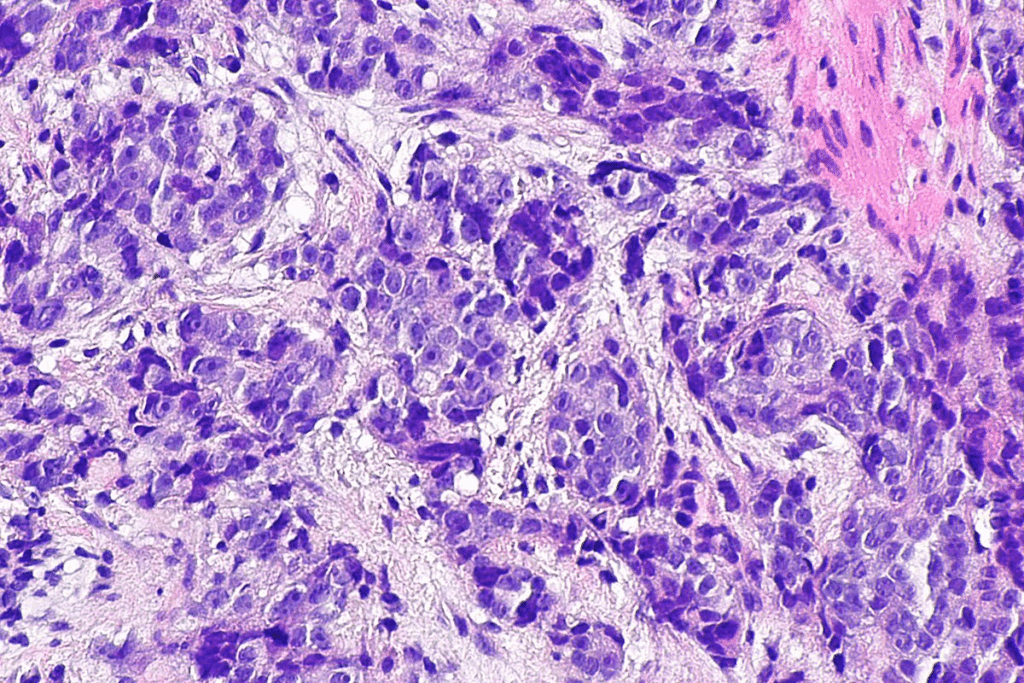
Moderate Bacteria in Urine: How to Interpret Results 3 Moderate Bacteria in Urine: How to Interpret Results

Understanding urinalysis results can be tough, moderate bacteria in your urine test being a big concern.How to read test results that show moderate bacteria in urine. Learn what this level indicates about a possible urinary tract infection.
Urine tests check for things like electrolytes, proteins, and bacteria. They give us clues about our health. Finding bacteria might make you think of a urinary tract infection (UTI).
At Liv Hospital, we focus on getting your health right. We make sure you get the right treatment, not just based on lab results.
Key Takeaways
- Urine tests can reveal various health issues, including infections and other conditions.
- The presence of bacteria in urine doesn’t always indicate a UTI.
- Accurate interpretation of urinalysis results is key for the right treatment.
- Liv Hospital’s approach focuses on clinically indicated care decisions.
- Understanding your test results can help ease your worries.
Understanding Urinalysis: The Basics of Urine Testing

Urine testing, or urinalysis, is a common test used to find problems in urine. It helps us learn about a patient’s health. This is key for diagnosing and tracking different health issues.
Components of a Complete Urinalysis
A complete urinalysis checks many things, like pH and glucose levels. It also looks for bilirubin, nitrite, and protein. These tests show the physical and chemical makeup of urine.
Component | Description | Significance |
pH | Measures the acidity or alkalinity of urine | Helps identify conditions such as kidney stones or urinary tract infections |
Specific Gravity | Compares the density of urine to water | Indicates the concentration of waste products in urine |
Nitrite | Detects the presence of bacteria | Suggests a urinary tract infection |
Leukocytes | Identifies white blood cells in urine | Indicates an inflammatory response or infection |
As shown in the table, a complete urinalysis involves multiple tests. These tests together give a full picture of urinary health.
Why Bacteria Detection Matters
Finding bacteria in urine is key because it can mean a urinary tract infection (UTI). UTIs happen when bacteria get into the urinary system. This can cause pain, needing to pee a lot, and feeling like you need to pee right away.
“The presence of bacteria in urine is not always indicative of infection; it can also result from contamination during sample collection.”
— Clinical Microbiology Reviews
So, when we find bacteria in urine, we must think about the bigger picture. We might need to do more tests, like a urine culture.
Knowing about urinalysis and bacteria detection helps doctors make better choices for their patients.
Bacterial Measurements in Urinalysis: Quantification Methods
Understanding bacterial measurements in urinalysis is key for accurate diagnosis and treatment. We use precise methods to find out if and how much bacteria are in the urinary tract.
There are several ways to measure bacteria in urine, with microscopic examination being a main one. This method lets lab techs see and count bacteria in the urine sample.
Microscopic Examination Techniques
Microscopic techniques prepare a urine sample on a slide for a microscope look. It helps identify bacteria’s presence, amount, and type. Bacteria are often counted per high-power field (HPF).
To get more accurate counts, labs might use staining like Gram staining. The choice of method depends on the lab’s tools and the test’s needs.
Reporting Standards for Bacteria
Bacteria in urine are reported in terms like scant, some, moderate, many, and numerous. These terms give a rough idea of the bacterial load.
Reporting standards can differ slightly between labs. But, moderate bacteria usually mean a lot of bacteria, needing more checks. Below is a common reporting standard used in many labs.
Descriptive Term | Bacterial Quantity per HPF |
Scant | 0-5 bacteria |
Some | 5-10 bacteria |
Moderate | 11-50 bacteria |
Many | 51-100 bacteria |
Numerous | >100 bacteria |
It’s important to understand these results with the patient’s symptoms and other lab findings. Finding moderate bacteria doesn’t always mean a UTI. But, it does mean more tests are needed.
What Moderate Bacteria in Urine Actually Means
It’s important to know what moderate bacteria in urine means for your health. A urinalysis report showing moderate bacteria means there’s a certain amount of bacteria present. This amount needs to be understood correctly.
Defining the Range of Moderate Bacteria Levels
Moderate bacteria in urine means there are bacteria in a certain range. This range is usually between 4 to 50 bacteria seen under a microscope. Here’s a quick guide to bacterial amounts in urinalysis reports:
- Few: 1-3 bacteria per visual field
- Moderate: 4-50 bacteria per visual field
- Many: More than 50 bacteria per visual field
Comparison to Other Bacterial Quantity Descriptors
Knowing how moderate bacteria compares to other levels is key. The terms “few,” “moderate,” and “many” help doctors quickly understand the severity of bacterial presence. For example:
Bacterial Quantity Descriptor | Bacteria per Visual Field | Clinical Implication |
Few | 1-3 | May indicate contamination or early infection |
Moderate | 4-50 | Could signify a developing infection or contamination |
Many | >50 | Often associated with significant bacteriuria or urinary tract infection |
By comparing these levels, doctors can understand the importance of moderate bacteria in urine. This helps them decide on the right tests or treatments.
Interpreting Moderate Bacteria Findings in Context
When a urine test shows moderate bacteria, we must look at it with other test results and symptoms. It’s key to understand the bigger picture to know if this finding is important.
Clinical Significance vs. Laboratory Findings
Lab results, like moderate bacteria, need to be seen with the patient’s symptoms. We must tell apart findings that suggest an infection from those that don’t. For example, if someone has symptoms like painful urination, it might mean a UTI. But if there’s no pain, it might not need treatment.
Normal vs. Abnormal Bacterial Presence
It’s important to know what’s normal versus abnormal in urine bacteria. Usually, urine is clean, but it can get contaminated. If there’s more bacteria than usual, it could mean an infection, like if there are also white blood cells in the urine. We look at the whole picture to understand the bacteria’s meaning.
Contamination vs. True Bacteriuria
Telling contamination from true bacteriuria is a big step in understanding test results. Contamination happens when the sample is taken wrong and can lead to false positives. True bacteriuria means bacteria are in the urinary tract. We figure this out by looking at the bacteria type, symptoms, and other test results.
When we see moderate bacteria, we also check other test results like white blood cells and nitrite tests. This helps us understand the patient’s health better. By looking at all these, we can make better diagnoses and treatment plans.
Critical Urinalysis Parameters That Accompany Bacterial Findings
The presence of bacteria in urine is just one piece of the puzzle; other urinalysis parameters provide valuable context.
When interpreting bacterial findings, several other urinalysis parameters come into play. These include white blood cell count, leukocyte esterase, nitrite tests, and various chemical indicators.
White Blood Cell Count
The white blood cell (WBC) count in urine is a key indicator of infection. A high WBC count often means a bacterial infection in the urinary tract. This helps tell if it’s a real infection or just contamination.
In urinalysis, WBCs are counted under a microscope. More than 5-10 WBCs per high-power field is abnormal. It may show a urinary tract infection (UTI).
Leukocyte Esterase and Nitrite Tests
Leukocyte esterase and nitrite tests are key chemical tests in urinalysis. Leukocyte esterase is an enzyme from WBCs, showing inflammation, possibly from infection.
The nitrite test looks for nitrites, made by some bacteria like Escherichia coli. This test is good for finding bacterial infections.
Both tests help make UTI diagnosis more accurate. A positive result in either or both, with bacterial findings, confirms a UTI.
pH and Other Chemical Indicators
Urine pH is important when looking at bacterial findings. Some bacteria, like those causing struvite stones, change urine pH. An abnormal pH may show an infection or other urinary issues.
Other chemical indicators, like protein, glucose, and ketones, are also important. Protein or blood in urine might mean a bacterial infection. Glucose in urine could mean diabetes, which raises UTI risk.
By looking at all these urinalysis parameters, healthcare providers can understand a patient’s urinary health better. This helps make more accurate diagnoses.
The Relationship Between Moderate Bacteria and UTI Diagnosis
Moderate bacteria in a urine test doesn’t always mean you have a UTI. Other signs and symptoms must be looked at too. Doctors use many factors to decide if you have a urinary tract infection.
When Moderate Bacteria Indicates Infection
Moderate bacteria in a test might mean a UTI if you have other symptoms. These symptoms include:
- Dysuria (painful urination)
- Frequent urination
- Urinary urgency
- Suprapubic discomfort
- Presence of white blood cells (leukocytes) in the urine
A positive nitrite test or leukocyte esterase test also helps confirm a UTI with moderate bacteria.
When Moderate Bacteria May Not Be Clinically Significant
At times, moderate bacteria might not mean a UTI. This can happen if:
- The sample got contaminated during collection
- You have asymptomatic bacteriuria, where bacteria are present but you don’t feel sick
- The bacteria are just colonizing without causing an infection
It’s important to check if moderate bacteria in a test is really a problem.
Asymptomatic Bacteriuria vs. Symptomatic UTI
Distinguishing between asymptomatic bacteriuria (ASB) and a symptomatic UTI is key. ASB means bacteria in urine without symptoms. A symptomatic UTI has both bacteria and symptoms.
Characteristics | Asymptomatic Bacteriuria | Symptomatic UTI |
Bacteria Presence | Yes | Yes |
Symptoms | No | Yes |
Clinical Significance | Generally not treated | Treated with antibiotics |
Knowing the difference between ASB and a symptomatic UTI is important for the right treatment.
Urine Culture: The Definitive Test After Positive Urinalysis
After a urinalysis shows bacteria, a urine culture is done. It gives a clear diagnosis and a treatment plan. This test finds the exact bacteria causing the infection and picks the best antibiotic.
Colony-Forming Units (CFUs) Explained
CFUs are key in a urine culture. They show how many live bacteria are in the urine. A high CFU count means a big infection.
Interpreting CFU counts: Over 100,000 CFUs/mL means a big infection. Between 10,000 and 100,000 CFUs/mL might also be a problem. But, a low count doesn’t always mean it’s just contamination.
Bacterial Species Identification
A urine culture not only counts bacteria but also finds out what kind they are. Knowing this helps pick the right antibiotic.
Common urinary pathogens: E. coli causes most UTIs, about 80-90%. Other bacteria like Klebsiella and Proteus can also cause infections.
Antibiotic Sensitivity Testing
After finding the bacteria, testing shows which antibiotics work best. This helps doctors choose the right treatment.
Understanding sensitivity reports: The test shows if bacteria are sensitive, intermediate, or resistant to antibiotics. Sensitive means the antibiotic works well. Resistant means it doesn’t.
With CFU counts, bacterial identification, and antibiotic testing, doctors can treat UTIs well. This ensures patients get the best care.
Special Considerations for Different Patient Populations
Healthcare providers must think about the unique needs of different patients. This includes pregnant women, the elderly, kids, and those with weakened immune systems. Each group needs special attention when looking at urinalysis results.
Interpreting Results in Pregnant Women
Pregnant women face a higher risk of urinary tract infections. These infections can cause serious problems like preterm labor and kidney infections. It’s important to watch for even small signs of infection in pregnant women.
Elderly Patient Considerations
UTIs in older adults can be tricky to spot. They might not show symptoms like pain or frequent urination. Instead, they might act confused or have falls. We need to be careful when looking at urinalysis results for older adults.
Pediatric Urinalysis Interpretation
When it comes to kids, we have to think about their age. Young children might not be able to give a clean urine sample. This makes it harder to get accurate results. We also need to know what’s normal for different ages in kids.
Immunocompromised Patient Evaluation
People with weakened immune systems, like those with HIV or on chemotherapy, are more likely to get UTIs. When we look at their urinalysis results, we should watch for unusual infections. Sometimes, we might need to do more tests.
To show how different patients need different care, here’s a table:
Patient Population | UTI Risk Factors | Interpretation Considerations |
Pregnant Women | Increased risk of UTIs, possible complications | Treat even small infections, watch for UTI signs |
Elderly Patients | Unusual symptoms, hidden infections | Look for odd symptoms, possible hidden infections |
Pediatric Patients | Hard to get clean samples, age-based norms | Consider age, possible contamination |
Immunocompromised Patients | Higher risk of UTIs, unusual infections | Watch for odd infections, might need more tests |
By knowing these special needs, doctors can better understand urinalysis results. This helps them give the right care to their patients.
Home UTI Tests vs. Laboratory Urinalysis
It’s important to know the difference between home UTI tests and lab urinalysis for accurate diagnosis. Home tests are easy to use, but lab tests give a detailed analysis of urine samples.
Limitations of Home Testing
Home UTI tests aim to find signs of a urinary tract infection in urine. But, they have some big limitations. They might not catch all bacteria or show how serious the infection is. Also, mistakes in using the test can lead to wrong results.
For example, if the test strip isn’t used right or if the results aren’t read on time, they can be wrong. Home tests also don’t tell you if the bacteria can be treated with antibiotics, which is key for treatment.
When to Seek Professional Laboratory Testing
Home UTI tests are good for a first check, but sometimes you need a lab test. If you keep getting UTIs or if your symptoms don’t get better, you should get a lab test.
Lab tests give a detailed look, like what bacteria you have and if it’s resistant to antibiotics. This info is important for choosing the right treatment.
Understanding Discrepancies Between Test Results
Home UTI tests and lab tests might not always match because of different sensitivities and specificities. The time of the test, how the sample is taken, and how it’s handled can also affect the results.
If your results don’t match, talk to a doctor. They can understand your symptoms and medical history. They’ll decide what to do next and if more tests are needed.
Next Steps After Receiving Moderate Bacteria Results
If your urinalysis shows moderate bacteria, it’s important to understand what it means. This result could point to a urinary tract infection (UTI) or another issue that needs medical help.
When to Contact Your Healthcare Provider
If you get moderate bacteria results, it’s key to talk to your healthcare provider. This is true if you’re feeling pain when you pee, need to pee a lot, or have stomach pain. They will check your health and decide what to do next.
It’s also wise to contact your healthcare provider if you often get UTIs, are pregnant, or have a weak immune system. These situations can make infections worse.
Questions to Ask About Your Results
When you talk to your healthcare provider about your results, ask these questions:
- What does it mean to have moderate bacteria in my urine?
- Do I need more tests, like a urine culture?
- What treatments are there for a UTI?
- Are there any changes I can make to avoid UTIs in the future?
Follow-up Testing Recommendations
Your healthcare provider might suggest more tests to confirm a UTI or find out what bacteria you have. A urine culture is often used to find out more about the bacteria and choose the right antibiotics.
It’s very important to follow your healthcare provider’s advice on further testing and treatment. This helps make sure your condition is handled right.
Conclusion: Putting Moderate Bacteria Findings into Perspective
Understanding moderate bacteria in urine test results is key for correct diagnosis and treatment. We’ve looked at what affects urinalysis results. This includes bacterial counts, symptoms, and the type of patients.
When we see moderate bacteria, we need to look at the bigger picture. It might mean a urinary tract infection (UTI). But, it’s not the only clue. We also check other tests like white blood cell count and nitrite tests to fully understand the situation.
In short, moderate bacteria in urine tests need careful thought. By knowing how to read these results, we can give better diagnoses and treatments. If you see moderate bacteria, always talk to a doctor to figure out what to do next.
FAQ
What does “moderate bacteria” mean in a urine test result?
“Moderate bacteria” in a urine test means there’s a lot of bacteria. This might mean you have a urinary tract infection (UTI). But, it really depends on your symptoms and other test results.
How is bacterial quantity measured in urinalysis?
To measure bacteria in urinalysis, we use a microscope. We count bacteria per high power field (HPF). Then, we say there are few, moderate, or many bacteria.
What is the difference between asymptomatic bacteriuria and symptomatic UTI?
Asymptomatic bacteriuria means bacteria in urine without symptoms. Symptomatic UTI means bacteria and symptoms like pain or needing to pee a lot. Asymptomatic might not need treatment, but symptomatic UTI usually does.
What other urinalysis parameters are important when bacteria are present?
When bacteria are found, we also look at white blood cells, leukocyte esterase, and nitrite tests. These help us see if there’s an infection and how the body is reacting.
How does urine culture confirm UTI diagnosis?
Urine culture confirms UTI by finding the bacteria causing the infection. It also shows how many bacteria there are and which antibiotics work best.
Are home UTI tests as reliable as laboratory urinalysis?
Home UTI tests are not as good as lab tests. They might miss some bacteria or not give all the details we need.
What should I do if I receive moderate bacteria results?
If you get moderate bacteria results, talk to your doctor. They’ll help you understand what it means and what to do next. It’s important to know what to do based on your situation.
How do urinalysis results differ in various patient populations?
Results can vary a lot between different groups, like pregnant women or the elderly. This is because their bodies and health can affect how we interpret the results.
What questions should I ask my healthcare provider about my urinalysis results?
When talking to your doctor about your results, ask about what they mean for you. Find out if you need more tests or treatment. Also, ask about any lifestyle changes or follow-up you might need.
References
- Mandel, I., Dykstra, J., & Mandel, K. S. (2020). Urinalysis. In StatPearls. StatPearls Publishing.https://www.ncbi.nlm.nih.gov/books/NBK557685/